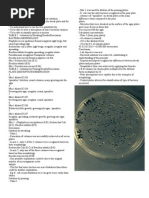
Download Streaking Methods by chocoholic potchi SN17275897 doc pdf

- Resep Masakan Dan Kue by bimma zaxtie SN:9767257
- Chapter 2 Related Literature and Studies This by chocoholic potchi SN:26759695
- RESEP KUE by Ayu Kamiya SN:54048141
- Black Forest Ny Liem (Autosaved) by masdarx SN:230782453
- RA 5527 by chocoholic potchi SN:17276299
- Chapter 3 Methods and Procedures This Chapter by chocoholic potchi SN:26759672
- RESEP MPASI 1 Tahun by Fauzia Nana Asnasari SN:39149020
- PENGERTIAN MAKANAN KONTINENTAL.docx by Puspita Dwi Lestari SN:242672533
- Chapter 1 the Problem and Its Background by chocoholic potchi SN:26759692
- Streaking Methods by chocoholic potchi SN:17275897
- Integrated Method (Fwr) (1) by chocoholic potchi SN:36884744
- Typhidot Assay by chocoholic potchi SN:28339894
- Organizing and Staffing by chocoholic potchi SN:18233857
- Document by Jaziel Ah SN:54749721
- RESEP by Symfoni Dhiyaztari SN:49569132
- Cryptococcal Antigen Latex Agglutination test JOSEPH.ppt by chocoholic potchi SN:28340032
- GROUP 1- Sweat and Urine by chocoholic potchi SN:28533505
- LECTURE CLINICAL ENZYMOLOGY.pptx by chocoholic potchi SN:28340121
- Ascaris lumbricoides by chocoholic potchi SN:17276263
- Lab 0207 by chocoholic potchi SN:17275890
- Fungi Classification 09 by chocoholic potchi SN:25967797
- 6. Tissue Sectioning & Cutting by chocoholic potchi SN:35501719
- Resep Masakan by Racy Highlydreamer SN:50172522
- HEMATOLOGY CASE STUDIES by chocoholic potchi SN:35502850
- tests for dengue GROUP 3.ppt by chocoholic potchi SN:28339903
- 9. Applications of Microbial Genetics by chocoholic potchi SN:17276218
- Filariasis Phil. by chocoholic potchi SN:18430633
- FWR Teaching Methods by chocoholic potchi SN:36884743
- Cases for Post Prelims Conference 2009-2010 by chocoholic potchi SN:24209242
- Rheumatoid Factor Latex test partolan.ppt by chocoholic potchi SN:28340124
Arsip Blog
-
▼
2019
(1414)
-
▼
Februari
(430)
- Daftar Resep Lumpia Goreng Semarang
- Kumpulan Pengertian Metode Gravity
- Kumpulan Tutorial Lightroom Mac
- Contoh Resep Masakan Korea Berkuah
- Kumpulan Manfaat Pasar Uang Bagi Pemerintah
- Download Belajar Perkalian Untuk Anak Tk
- Download Resep Kue Tart Vanila Simpel
- Contoh Pengertian Konsep Tema Karya Cipta
- Contoh Menu Diet Mayo Mudah
- Daftar Metode Sterilisasi Fisik Dan Kimia
- Contoh Pengertian Frekuensi Dalam Seni Musik
- Download Tips Langsing Miranda Kerr
- Contoh Kumpulan Trik Picsart
- Koleksi Belajar Drum Avenged Sevenfold
- Daftar Metode Komparatif Hukum
- Contoh Contoh Soal Laju Reaksi Kelas 11
- Daftar Teori Harga Pertanian
- Download Ayam Masak Lemak Kuning Resipi
- Daftar Contoh Laporan Latihan Industri Politeknik ...
- Contoh Sistematika Karya Ilmiah Non Penelitian
- Download Video Belajar Wushu
- Contoh Soal Tes Pramugari Garuda
- Koleksi Pemanfaatan Energi Tata Surya
- Contoh Makalah Biologi Yoghurt
- Kumpulan Masuk Fb Sandi Lama
- Kumpulan Pengertian Analisis Swot Ppt
- Kumpulan Contoh Laporan Pkl Keperawatan Komunitas
- Daftar Makalah Organisasi Organisasi Kb Di Indonesia
- Download Teks Prosedur Komplek Cara Membuat Visa
- Daftar Skripsi Tentang Lembaga Pendidikan
- Koleksi Resep Rendang Sapi
- Download Khasiat Daun Sirih Merah Untuk Obat Batuk
- Contoh Contoh Soal Integral Fungsi Trigonometri Da...
- Kumpulan Belajar Excel Hyperlink
- Contoh Contoh Soal Spldv Dengan Metode Invers Matriks
- Koleksi Kat.Cr Boruto Naruto The Movie
- Daftar Masak Resep
- Koleksi Kumpulan Soal Osn Biologi Smp Tingkat Kabu...
- Koleksi Tips Usaha Jasa Pengetikan
- Daftar Latihan Soal Psikotes Masuk Smp
- Daftar Resep Masakan Kepiting Goreng Saus Tiram
- Kumpulan Makalah Lengkap Tentang Bahaya Narkoba Pa...
- Daftar Ebook Tentang Kedokteran
- Contoh Contoh Teks Undangan Informal Dalam Bahasa ...
- Daftar Cara Membuat Presentasi Powerpoint 2007
- Contoh Node Js Beginner Tutorial Pdf
- Koleksi Instalasi Sistem Operasi Dengan Metode Upg...
- Daftar Pengertian Objektif Dan Subjektif Dalam Bah...
- Koleksi Contoh Proposal Bisnis Plan Toko Buku
- Contoh Cara Tune Up Rx King Harian
- Download Masak Kerang Cabe Hijau
- Daftar Manfaat Labu Siam Untuk Ibu Hamil
- Download Teori Kepemimpinan Lingkungan
- Koleksi Pengertian Fungsi Dan Relasi
- Daftar Resep Kulit Risoles Yg Empuk
- Contoh Tips Lari Lama
- Daftar Tips Pdkt Melalui Chat
- Download Resep Cumi Hitam Kering
- Koleksi Pengertian Hukum Menurut 3 Orang Ahli
- Koleksi Pengertian Anggaran Dalam Sistem Pengendal...
- Contoh Cara Ampuh Menghilangkan Jerawat Kaskus
- Contoh Pengertian Larutan H2O2
- Daftar Resep Masakan Sop Iga Sapi
- Koleksi Resep Kue Gula Merah Kukus
- Contoh Trik Gratis Nelpon Axis 2016
- Daftar Contoh Soal Cerpen Dan Pantun
- Daftar Hacker Masuk Fb
- Download Soal Dan Jawaban Yang Mengasah Otak
- Daftar Metode Ahp Dalam Sistem Pendukung Keputusan
- Kumpulan Fl Studio 12 Guitar Rig
- Daftar Contoh Minit Mesyuarat Teknikal
- Kumpulan Belajar Membaca Iqro 1 Sampai 6
- Daftar Belajar Php Smarty
- Contoh Kalimat Pembuka Acara Presentasi
- Koleksi Resep Makanan Penderita Batuk
- Koleksi Menu Diet Untuk Mahasiswa
- Download Pengertian Marketing Insight
- Daftar Contoh Soal Biaya Produksi Per Unit
- Koleksi Belajar Autocad Berapa Lama
- Daftar Resep Chocolate Lasagna Untuk Chocoholic
- Download Resep Olahan Jamur Tiram Enak
- Kumpulan Pengertian Warna Vintage
- Koleksi Makalah Observasi Gizi
- Daftar Belajar Bahasa Jepang Lengkap
- Download Pengertian Keluarga Yang Harmonis
- Kumpulan Resep Gado Gado Sederhana
- Daftar Prosedur Analitis Pada Siklus Penjualan Dan...
- Koleksi Pengertian Hak Interpelasi Dprd
- Daftar Contoh Teks Pembuka Khutbah
- Koleksi Contoh Soal Pilihan Ganda Limit Fungsi Dan...
- Contoh Kamus Belajar Bahasa Batak
- Daftar Tips Sms Lucu
- Daftar Cara Tutorial Rambut Pendek
- Daftar Resep Masak Ceker Ayam Enak
- Koleksi Pengertian Bid'Ah Sesungguhnya
- Kumpulan Masak Ikan Laut
- Daftar Prosedur Rujukan Jamkesmas
- Download Contoh Abstrak Laporan Resmi
- Daftar Resep Membuat Kue Menggunakan Happy Call
- Contoh Manfaat Daun Kelor Untuk Liver
- Contoh Tips Dan Trik Gta Vice City Android
- Daftar Ebook Gitar
- Daftar Kiatisuk Senamuang Ganteng
- Daftar Pengertian Iman Menurut Ulama Tauhid
- Daftar Makalah Iman Kepada Allah Dan Malaikatnya
- Contoh Prosedur Nikah Jawi
- Kumpulan Prosedur Kerja Operasi Hernia
- Download Belajar Forex Permulaan
- Daftar Pengertian Nilai Luhur Pancasila
- Kumpulan Cara Memasak Harvest Moon Psx
- Contoh Makalah Tentang Bhakti Yoga
- Koleksi Pengertian Bentuk Akomodasi Koersi
- Daftar Susunan Skripsi Teknik Elektro
- Contoh Teori Domino Blok Barat
- Koleksi Belajar Menggambar Kota
- Contoh Trik Get Rich Event
- Kumpulan Contoh Soal Program Linear Dengan Jawabannya
- Kumpulan Resep Kue Pepe Lapis Beras
- Download Makalah Kewirausahaan Rental Playstation
- Download Tutorial Eyebrow Pencil Wardah
- Koleksi Arti Asmaul Husna Ya Ghofur
- Kumpulan Unity Tutorial Basic Game
- Contoh Tips Langsing Miranda Kerr
- Contoh Cara Memasak Ikan Sambal Mangga
- Contoh Belajar Software Pada Laptop
- Contoh Resep Masakan Pindang Jawa
- Daftar Tutorial Make Up Garnier
- Daftar Cara Sulam Eyeliner
-
▼
Februari
(430)
Diberdayakan oleh Blogger.
Mengenai Saya
Jumat, 22 Februari 2019
Daftar Resep Chocolate Lasagna Untuk Chocoholic
Langganan:
Posting Komentar (Atom)
Cari Blog Ini
-
contoh proposal usaha by iloveu_dear SN:3176033 contoh proposal usaha.pdf by Lasiman Mulyana...
-
Makalah Alel Ganda by Yudha Setyo Pratama SN:144438085 Laporan Praktikum Genetika-Alel Ganda...
-
Basic--[2] Oracle Reports 10g Tutorials by rutvipatel SN:3960412 HP Quality Center Installat...

Tidak ada komentar:
Posting Komentar